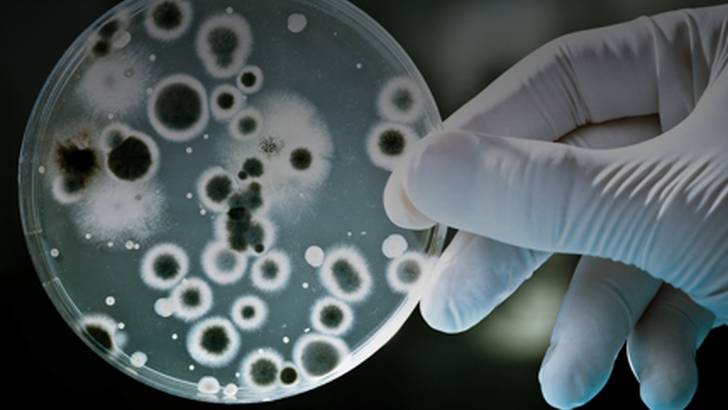
ReachMD Healthcare Image

After failed attempts to infect piglets with H.pylori in 1984, Dr. Barry Marshall decided to use himself as an animal model and drank from a petri dish cultured with the bacteria. His resultant development of gastritis, and the subsequent discovery of H.pylori's role in gastric ulcer disease pathogenesis, led to a Nobel Prize in Physiology or Medicine in 2005. On this program, Dr. Marshal shares his personal story of discovery with host Dr. Mary Leuchars.
The Remarkable Discovery of Helicobacter pylori
Dr. Mary Leuchars:
After failed attempts to infect piglets with helicobacter in 1994, Dr. Barry Marshall decided to use himself as an animal model and drank a petri dish full of bacteria. The rest is history.
You're listening to ReachMD, the channel for medical professionals. Welcome to the Clinician’s Roundtable. I'm Dr. Mary Leuchars, your host. Joining me today from Perth. Western Australia is Professor Barry Marshall. Nobel Laureate and Professor of Clinical Microbiology at The University of Western Australia.
Today we’re talking about his very personal discovery of Helicobacter Pylori and its role in the pathogenesis of peptic ulcer disease.
Welcome, Barry, and thanks for joining us.
Professor Barry Marshall:
Hi there, Mary.
Dr. Mary Leuchars:
So, how did your childhood and early medical career lead you towards the study of helicobacter and gastroenterology?
Professor Barry Marshall:
That’s a hard one to answer. I tell a story of when I was…in the 50s when the polio vaccine first came out, must have been about 1956, I remember I was walking along with my mother and we were heading to get my vaccination, and we walked past a house with two cars parked on the front lawn, and I said, “hey, mum. How come they’ve got two cars?” And she said, “He’s a doctor dear.” So, maybe that made an impression, but I can remember that day.
But my father was a fitter, a mechanical fitter and a diesel engineer and worked on caterpillar tractors, whaling stations, and boats, refrigeration, and always had a lot of technical books around the house. And my mother was a nurse, so the other books I had to look at were nursing books. And so you might not remember what it was like, but in the 50s, there were not very many books at all in an Australian house, so I probably had more than most and I probably read every single one of them cover to cover by the time I was 9 years old.
Dr. Mary Leuchars:
So you started your career in medicine as a general physician?
Professor Barry Marshall:
That’s true. I was doing internal medicine training and I was just into my first year of three years clinical when I started meeting up with the helicobacter if you like.
Dr. Mary Leuchars:
And how did your association with Robin Warren begin?
Professor Barry Marshall:
Well, I had a random rotation for 6 months through gastroenterology, not as a gastroenterology trainee, but as an internal medicine with the Award Registrar. So sort of a general medicine rotation, and part of the thing you have to do in Western Australia is a clinical research project for each of the three years in your physician training.
The project I chose was to follow up the clinical side of about 20 patients that Dr. Warren had seen who had ________ (00:02:29) bacteria in their biopsies, so my boss said, “go down and see Dr. Warren. He’s got these interesting bacteria. No one believe their important, but why don’t you just see if there's anything associated with them?” So I spent an afternoon there with Robin Warren. He was teaching me all about gastritis, showing me these bacteria, and at the end of the afternoon I decided that it was quite an exciting project because bacteria supposedly didn’t live in the stomach It was acidic and sterile as far as everyone was concerned. There's no reports of bacteria in the human stomach. Bacteria in the stomach was not associated with any disease, and possibly Robin Warren believed that they were associated with inflammation which was gastritis. So it was a curious association and the exciting idea was maybe this is a weird Australian disease, you know spread by koala bears or kangaroos or something. So it was a wide open research project without any specific goal.
Dr. Mary Leuchars:
At the time, what was the patient burden of the disease in Australia, in the western part of Australia where you worked?
Professor Barry Marshall:
When we studied 100 people, 60 of them had the helicobacter, approximately 60 or 57, some number like that, so of all patients coming to endoscopy, the majority of them had the helicobacter. When we then tested blood donors, we found that about 40 percent of the population had it.
Dr. Mary Leuchars:
And at the time, do you remember what the comparable rates were worldwide? For example, in North America?
Professor Barry Marshall:
It was similar in the US and a few years after we started reporting it, there was a study, I think from San Francisco or California, Kaiser Serology Banks were examined back into the 60s, and apparently about 1966 or 67, the prevalence of H pylori in California in men, aged about 40 years was 60 percent is my recollection, but more than 50 percent. So in the 60s, at least, you could say even in California, more than half the population was infected with pylori. And this is probably upper socioeconomic group at that time, because these people had private insurance.
Dr. Mary Leuchars:
And at the time, when you started working with Robin Warren, did you have a name for the bacteria?
Professor Barry Marshall:
People say why didn’t you name it after yourself, but one of the reasons might have been that we suspected that it was a venereal disease or sexually transmitted, because it was more common in ladies attending the STD clinic, for example, at least serologically. But there was probably a socioeconomic thing.
We then called it campylobacter because campylobacter means curved bacteria, and it looks very similar under the microscope, but on electro-microscopy, it has different kind of flagellum shape. It’s not a simple flagellum like a normal campylobacter, but we called it campylobacter and we called it pyloridus, which means at the pylorus, or near the pylorus.
Unfortunately, we had to change the name several times because their classical scholarship was not all that great and the Greek scholars were arguing with the Roman scholars and we had Greek mixed up with Latin in the name and we had to be consistent. So I think, ultimately it was called helicobacter which is spiral bacteria, and pylori which means of the pylorus and it’s a Greek one.
Dr. Mary Leuchars:
So, who decided that in the end?
Professor Barry Marshall:
Well one of the professors who is an editor of the Journal of Clinical Bacteriology, I think or one those ASM journals.
Dr. Mary Leuchars:
If you're just joining us, you're listening to ReachMD, the channel for medical professionals. I'm Dr. Mary Leuchars, your host, and today I'm talking with Nobel Laureate, Professor Barry Marshall from The University of Western Australia, and we’re discussing how he proved that H pylori causes ulcer disease by infecting himself.
So, Barry, you’ve got to tell us the story about drinking the helicobacter. How did it happen?
Professor Barry Marshall:
Well, you know, I was a bit shy about it, because it’s a bit embarrassing to say that you're experimenting on yourself. People thought I was a little bit eccentric anyway with this idea of bacteria causing ulcers. And so I didn’t tell very many people about it, but we cultured helicobacter from a man with gastritis. He didn’t actually have an ulcer. We tested against antibiotics to be sure that we could eradicate it, or thought we could, and then about a month later, I had an endoscopy that shows my stomach was normal, and the following week, I drank a petri dish of the bacteria, actually two petri dishes, dissolved in about 20 mLs of meat broth. On that day, I was fasting in the morning and about 10:30 in the morning…well, I took a couple of Tagamet tablets to knock off the excess gastric acid I thought I might have, and I scrapped two petri dishes right out of their plates into some meat broth, 20 mLs or so, and then held my nose and sculled it down and just like a shot of Tequila. So I didn’t’ really think too much about what it tasted like and everybody asked me what did it taste like, and I have to say, I'm not going to tell you because the paper’s being prepared and we’ll publish that next year sometime.
Dr. Mary Leuchars:
When you did this experiment, did you run this by an ethics committee?
Professor Barry Marshall:
I didn’t run it past the ethics committee, and I'm not quite sure what my thought processes were at that time. Whenever I published an abstract, a post, or gave an oral presentation, the experts would get up out of the audience and say, “Dr. Marshall, you’re wrong. People with ulcers then catch these harmless bacteria, which are so common, they couldn’t possibly be the cause of the ulcers. So it’s ulcers first, bacteria, contamination.” And I didn’t have an animal model, so you had to have an animal model to show that you could have a healthy animal infected with the bacteria, developing gastritis and then a peptic ulcer. So, it was a very important thing to prove, and the other experiments in pigs and mice had failed. At that stage, no one else had an animal model either, and so I said, if I'm right about this, then these bacteria should be able to infect a healthy human, because 40 percent of the population in my hometown has them. So it was an important experiment and it became more and more crucial because I had numerous papers rejected, I had presentations that weren’t accepted. It was very frustrating for me and I really needed to get on with my life. If I was wrong about this, well nothing would happen. But if I was correct, then I thought that I would develop asymptomatic gastritis and then maybe 6 months or a couple year later, Id develop a peptic ulcer. So I needed to know.
Dr. Mary Leuchars:
Did you try to get Robin Warren to drink it before you did?
Professor Barry Marshall:
Well, Robin and I discussed it and I can't remember why he chickened out. I think maybe he didn’t chicken out. Maybe he said that he already had the bacteria and therefore I couldn’t use him. I can't remember how I knew that. Perhaps we did his serology and then ruled him out.
Dr. Mary Leuchars:
And what about medical students?
Professor Barry Marshall:
Well, you would have had to have an ethics committee approval. The thing about the ethics committee, it was such an important experiment I could see that people’s lives were dependent on it, because remember peptic ulcer is a fatal disease. And if the treatment was going to be something simple like amoxicillin, there was only an upside to proving this. There was no downside as far as I could tell, and we needed to get the data out there as quick as possible. And so I decided that if I submitted to an ethics committee and they said no, what would happen then? I would still go ahead and do it and I’d probably be sacked. So it would be safer actually to not ask anybody and just do it quietly on myself and then decide what to do after that.
Dr. Mary Leuchars:
What did your wife say?
Professor Barry Marshall:
I tried to remember exact words but shock, horror, would probably be the correct answer. But she is a very thoughtful and sympathetic person, so she was immediately worried about me becoming unwell, developing an ulcer, and then she worried about the children being infected because I was off the second week. After the first week, I started throwing up in the morning, so she was thinking it was infectious. So at that point, she said, “This experiment can't go on any further. You have to take some antibiotics immediately.” But I did string it out for a few days so I could get some biopsies and get the diagnostic material, and then I started antibiotics. So it taught me a lot.
Dr. Mary Leuchars:
When you realized you made this discovery, who were your most notable detractors?
Professor Barry Marshall:
It was a funny situation because some of the most notable detractors were actually good scientists and they set out to prove me wrong, and immediately realized that they were getting the same data as me, and so within 12 months, my dangerous or notable detractors had changed sides and were really on my side. So after that 1985, even in the US, I gradually started collecting people who were interested and getting the same results doing the same research. But I can tell you that one of the first lectures I gave in the United States was actually in Dallas at I think Southwestern, and that was the headquarters of the group that had subsequently been called the acid mafia, who believed that everything was caused by acid, and nothing was caused by bacteria. And I turned up in the states and went down to Texas and gave a lecture there and they were very, very polite and I thought they really loved my lecture, but apparently they hated it, and set out to prove me wrong, but couldn’t do it. So that then a few years later a lot of publications on helicobacter were coming out of Dallas and they would be my staunchest supporters eventually.
Dr. Mary Leuchars:
Do you think the drug companies had any influence in hindering the progress of the discovery helicobacter?
Professor Barry Marshall:
They did indirectly because if you're share price depended on the old acid blocking treatment for ulcers, then you couldn’t really support research that was going to undermine the major product in your company, and so the best thing that they could do was ignore the possibility of bacteria causing ulcers, because if they said it wasn’t true or came out against it, they would just build the publicity, because in the US everyone likes a fight. Everyone likes a controversy. So as soon as something is controversial, it’s news. So the best thing they could do was pretend it didn’t exist and carry on with acid research. So that’s what happened for 5 or 6 years, and then it was impossible to keep the lid on it because everybody was excited about helicobacter and I know the American Gastro Association convention one year in New Orleans, must have been 1988 or 1989, and there were hundreds of posters on helicobacter. There were like rows and rows of them, and someone did an interview with me in front of the posters at a poster session, and as he was interviewing me on camera, and I didn’t realize I had a lapel mic stuck on, I had kind of forgotten about it, and they were just filming me walking, looking at the posters and somebody came up to me that I had never met before and they said, “Dr. Marshall. Congratulations. This is a great discovery. You and Dr. Warren are certainly going to win the Nobel Prize,” and I immediately pulled out my rabbits foot and started throwing salt over my shoulder, and touching wood, because I could say nothing could be worse of a jinx, I would think, than having your plans to win the Nobel Prize exposed on the news media.
Dr. Mary Leuchars:
Well, thanks very much, Professor Barry Marshall, for talking to us today. We’ve been discussing how you infected yourself with helicobacter and lived to tell the tale. I'm Dr. Mary Leuchars, your host. You’ve been listening to the Clinician’s Roundtable on ReachMD, channel for medical professionals. We welcome your comments and questions through our website at ReachMD.com, which now features our entire medical show library in on-demand podcasts.
Thanks for listening.
Ready to Claim Your Credits?
You have attempts to pass this post-test. Take your time and review carefully before submitting.
Good luck!
Overview
After failed attempts to infect piglets with H.pylori in 1984, Dr. Barry Marshall decided to use himself as an animal model and drank from a petri dish cultured with the bacteria. His resultant development of gastritis, and the subsequent discovery of H.pylori's role in gastric ulcer disease pathogenesis, led to a Nobel Prize in Physiology or Medicine in 2005. On this program, Dr. Marshal shares his personal story of discovery with host Dr. Mary Leuchars.
Title
Share on ReachMD
CloseProgram Chapters
Segment Chapters
Playlist:
Recommended
We’re glad to see you’re enjoying ReachMD…
but how about a more personalized experience?
